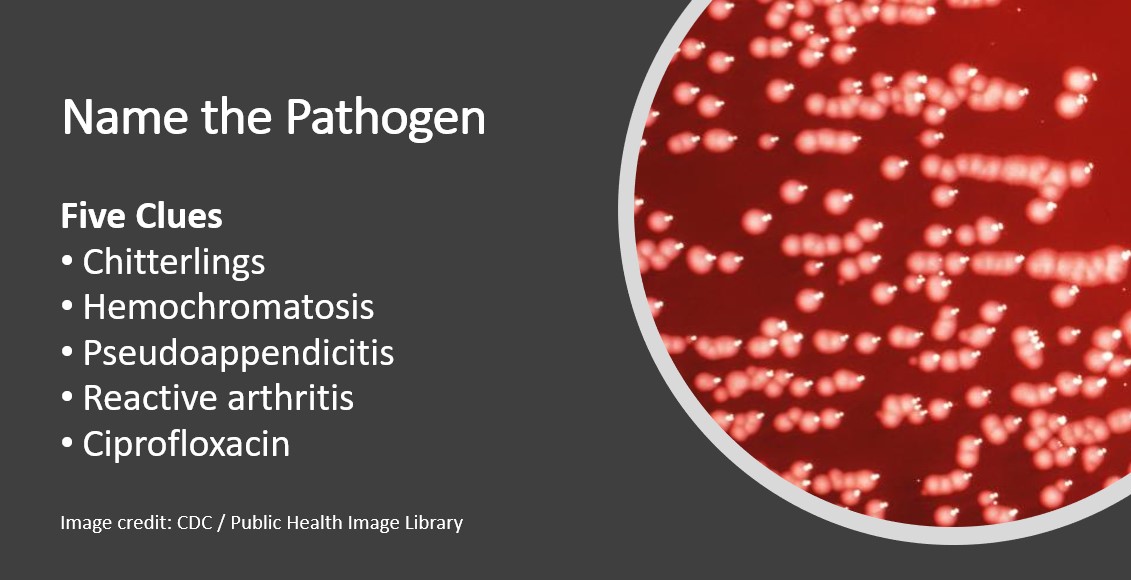

Invite to Our blog, an area where curiosity satisfies information, and where everyday subjects come to be engaging conversations. Whether you're looking for understandings on lifestyle, technology, or a bit of every little thing in between, you have actually landed in the right area. Join us on this expedition as we dive into the worlds of the ordinary and remarkable, making sense of the world one article at once. Your trip right into the fascinating and varied landscape of our How Easy Is It To Learn 3d Printing starts below. Check out the fascinating web content that awaits in our How Easy Is It To Learn 3d Printing, where we decipher the intricacies of various subjects.
How Easy Is It To Learn 3d Printing
How Easy Is It To Learn 3d Printing
Arabiclessons info T rkisch Lernen T rkische Sprache Sprachen Lernen

Arabiclessons info T rkisch Lernen T rkische Sprache Sprachen Lernen
Pin By Lou Sev On Japanisch Lernen Learn Japanese Words Japanese

Pin By Lou Sev On Japanisch Lernen Learn Japanese Words Japanese
Gallery Image for How Easy Is It To Learn 3d Printing

Strep Throat Medication

Convenient Bicycle Handlebar Light Mount Enhance Your Cycling

Como Editar Mensagens Do Discord

JP NewsS

Reviews By Janice s Amazon Page

Laravel

Laravel

How To Grow Ginger
Thanks for choosing to discover our web site. We best regards hope your experience surpasses your assumptions, which you uncover all the details and resources about How Easy Is It To Learn 3d Printing that you are seeking. Our dedication is to provide an user-friendly and interesting platform, so feel free to navigate through our pages easily.